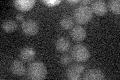
YNL040W
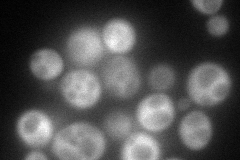
YNL040W
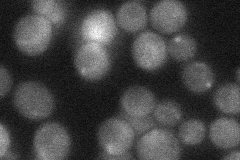
YNL040W

View description
Putative protein of unknown function with strong similarity to alanyl-tRNA synthases from Eubacteria; green fluorescent protein (GFP)-fusion protein localizes to the cytoplasm; YNL040W is not an essential gene
Localization:
Intensity:
Fold change:
Significance:
-
C’ GFP library in SD
below threshold17.16 -
N' NOP1pr-GFP in SD
cytosol113.532 -
N' TEF2pr-mCherry in SD

missing0 -
N' NATIVEpr-GFP in SD
cytosol32.3691 -
N' TEF2pr-VC and Cyto-VN in SD

#N/A0 -
C’ GFP library in SD+DTT

cytosol15.970.93No -
C’ GFP library in SD+H2O2

cytosolN/AN/ANo -
C’ GFP library in Starvation Media

cytosol13.60.79No -
C’ GFP library on the background of Pup2-DaMP

below threshold -
C’ GFP library on the background of CCT mutant

below threshold17.01330.991206No
